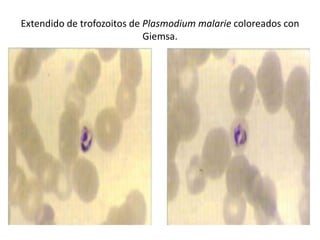
Extendido de trofozoitos de Plasmodium malarie coloreados con
                            Giemsa.

El documento describe diversas formas morfológicas de protistas patógenos, incluyendo trofozoitos y quistes de varias especies de Entamoeba, Endolimax, Iodamoeba, entre otros. También se mencionan otros organismos como Trichomonas, Leishmania y Trypanosoma, con información sobre sus características de tinción y diagnóstico. Se presentan ilustraciones de estas amebas y sus estados en infecciones humanas.